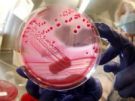

Большое количество микроорганизмов, живущих в окружающей среде, населяют и организм человека. Одни из них являются абсолютно безвредными и даже полезными, а другие, напротив, приводят к развитию серьезных патологий. Есть и такие, которые изначально являются полезными обитателями, но при определенных условиях начинают активно размножаться, вызывая воспалительную реакцию.
Специалисты называют такие микроорганизмы условно-патогенными. К их числу относят энтеробактерии. В их семейство входят кишечные палочки, клебсиелла эшерихия и другие. Кишечная палочка получила название Escherichia coli, так как впервые была выявлена немецким микробиологом Эшерихом. Бактерия длительное время обитает во влажной среде, а также в холодильнике и больничных условиях.
Ее обнаруживают в водоемах, на листьях деревьев, предметах обихода, в почве. Нейтрализация происходит после кипячения и обработки дезинфицирующими растворами. Виды кишечных палочек довольно разнообразны. Их объединяют в несколько основных групп, которые могут поражать кишечник. Они являются неотъемлемой частью нормального пищеварительного процесса и микрофлоры.
Патологическая активность этих бактерий проявляется в результате попадания инфекции. Некоторые виды этих микроорганизмов могут вызывать сильные расстройства ЖКТ и мочеполовой системы. Другие же являются непатогенными, то есть не вызывают развития инфекционных заболеваний.
Разновидности
Подавляющее число кишечных палочек не приносит организму вреда. Они научились сосуществовать вместе, принося пользу друг другу. Кишечник является главным резервуаром для обитания условно-патогенных штаммов Эшерихии коли.
Под действием определенных факторов нормальное содержание кишечной палочки снижается, в результате чего освободившееся пространство заселяется болезнетворными микроорганизмами. Это может происходить на фоне следующих причин:
- частые вирусные заболевания;
- недоразвитие лимфатических структур у маленьких детей;
- эмоциональное и физическое переутомление;
- возрастные изменения;
- ослабление иммунитета;
- вредные привычки: табакокурение, алкоголизм, наркомания.
Кишечная палочка делится на два основных вида: патогенные микроорганизмы, непатогенная микрофлора.Первая разновидность, в свою очередь, включает в себя:
- энтеропатогенные (штаммы вызывают диарею, особенно у грудничков);
- энтероинвазивные (проникают в более глубокие отделы кишечника, провоцируя кровавый понос);
- адгезивные. Прикрепляются к слизистой оболочке кишечника, нарушая всасывание питательных веществ;
- геморрагические. Выделяют антитела, повреждающие клеточные структуры;
- токсигенные (бактерия атакует слизистую оболочку внутренних органов и кровеносных сосудов) и другие бактерии. Непатогенные микроорганизмы бывают лактозопозитивными и лактозонегативными.
Вызвать отравление организма могут только патогенные штаммы. В норме кишечная палочка обеспечивает нормальную активность всего желудочно-кишечного тракта и способствует ограничению размножения болезнетворных микроорганизмов. Патогенные палочки после проникновения в организм провоцируют появление токсических веществ. В результате этого развивается сильная интоксикация организма.
Ультрафиолетовые лучи разрушают бактерии всего за несколько минут. Некоторое время они могут оставаться жизнеспособными в воде, земле, экскрементах, хорошо переносят высушивание. Эшерихия коли располагается преимущественно в толстом кишечнике. Там она участвует в таких процессах переваривания белков и углеводов, синтеза биотина, а также витаминов К и группы В, расщепления кислорода, переработки лактозы, переработки кислот, холестерина, билирубина.
Пути заражения
Эпидемиологические вспышки обычно возникают в летний период в теплых странах, особенно во время туристических сезонов. Кишечная палочка передается двумя основными путями:
- фекально-оральный. При контакте с почвой, водой, сельскохозяйственными культурами;
- контактно-бытовой. Чаще всего заражение происходит в коллективах.
После рождения ребенка E. Coli в течение первых сорока часов поступает в кишечник вместе с пищей. Заселив толстый отдел, она остается в нем на протяжении всей жизни. Проникновение болезнетворных микроорганизмов специалисты связывают с несоблюдением в должно мере правил гигиены. Употребление немытых овощей и фруктов, сырого молока, плохо прожаренной рыбы или мяса может привести к развитию кишечной патологии.
Вот почему часто симптомы кишечной палочки появляются у детей, чем у взрослых. Малыши в силу возраста до конца не понимают важности соблюдения гигиенических мероприятий. Гемолизированная кишечная палочка может находиться на сырых овощах, особенно если они выращиваются на земле, которая удобряется навозом. Если после контакта с заражённым животным не вымыть руки, существует риск инфицирования.
При несоблюдении правил гигиены эширихия коли легко попадает в мочевую систему, провоцируя развитие цистита. Особенно высок риск такого заражения у женщин. При проникновении в половые органы палочка может вызвать кольпит – воспаление влагалища. У мужчин она может послужить причиной простатита.
Симптоматика
Признаки эшерихоза во многом зависят от того, какие штаммы поразили желудочно-кишечный тракт (ЖКТ). Если организм поражен энтеротоксигенными палочками, симптомы интоксикации выражены слабо. Заболевание возникает остро с нарастающей слабости, разбитости и головокружения. При этом температура может даже сохраняться в пределах нормы. Живот вздутый, отмечаются схваткообразные боли.
Далее появляется диарея, тошнота, рвота. Эшерихиоз, вызванный энтеротоксигенными палочками, называют холероподобным, так как он по своим проявлениям похож на клиническое течение холеры легкой степени. Если же заболевание вызвали энтероинвазивные палочки, на первый план выходят общеинтоксикационные симптомы. Человека беспокоит слабость, озноб, головные боли, повышение температуры. Спустя какое-то время, появляются схваткообразные боли, а также диарея с примесями крови и слизи.
Энтеропатогенный эширихиоз у новорожденных может приобретать системный характер в виде сепсиса. Энтерогеморрагические палочки вызывают симптомы энтероколита. Появляется жидкий стул с кровью, а также боли в животе и тенезмы. Инкубационный период составляет от одного до пяти дней. Кишечная инфекция характеризуется нарастанием симптомов интоксикации.
К основным признакам развития патологической активности кишечной палочки можно отнести:
- слабость и недомогание;
- тошнота и рвота;
- диарея;
- фекалии приобретают желтый цвет;
- вздутие живота;
- сонливость и апатия;
- отсутствие аппетита;
- боль в области пупка.
Чаще всего кишечная палочка поражает именно пищеварительный тракт. Проявляется это в виде диареи до десяти–двенадцати раз в день. У пациентов также появляются ложные позывы к дефекации. Кал приобретает желтый вид с примесями слизи и небольшого количества пены. Обычно заболевание длится от трех до шести суток. У детей до года наблюдаются боли в животе, повышенное газообразование, тошнота, срыгивание, сонливость.
Заражение энтеротоксигенными палочками еще называют диареей путешественников. Чаще всего беспокоит людей, находящихся в другой климатической зоне. Недуг обычно длится всего несколько дней и проявляется в виде диареи, боли в области желудка, повышения температуры, тошноты, рвоты, вялости, головной боли.
Мочевыделительная система
Патогенные штаммы могут проникнуть в мочевыделительную систему несколькими путями:
- несоблюдение правил личной гигиены. Патогены могут проникнуть из заднего прохода во влагалище и мочеиспускательный канал. Также микроорганизмы могут распространиться из воспаленной вульвы или влагалища;
- восходящий путь. Возбудитель попадает в верхние отделы по мочевым каналам;
- гематогенное заражение. Эшерихии коли распространяются по кровеносной системе;
- лимфогенный путь, то есть по лимфатическим сосудам.
Причиной может послужить ношение тесно прилегающего нижнего белья. В итоге промежность потеет и патогенные микроорганизмы с легкостью переходят из аноректальной области во влагалище или промежность. Анальный секс – это еще одна причина заражения. Если половой член сначала проникает в анус, а затем во влагалище, таким образом, он переносит микрофлору из мочевой системы в половую сферу.
Специалисты также выделяют неблагоприятные факторы, которые способствуют задержке мочи в почках или мочевом пузыре: стриктуры, стенозы, извитость уретры. Сюда еще относится период беременности, когда увеличенная в размерах матка давит на мочевой пузырь.
Цистит, вызванный эшерихиями коли, проявляется такими симптомами: учащенное мочеиспускание, чувство неполного опорожнения мочевого пузыря, боли внизу живота, чувство жжения во время мочеиспускания. В урине будут появляться белые хлопья и осадок, она приобретает неприятный запах. Также часто обнаруживается кровь. Пациенты жалуются на общее недомогание, слабость, повышение температуры.
Возможно присоединение тошноты и рвоты. Лечение кишечной палочки во многом зависит от того, какой отдел мочевыделительной системы был поражен, а также какую форму и течение приобрёл патологический процесс. Для борьбы с заболеванием применяются антибиотики, уросептики, витамины, анальгетики, жаропонижающие средства.
В мазке из зева
Больных беспокоят боли в горле и постоянное першение. Лечение включает в себя применение антибиотиков и соблюдение диетического питания. Обязательно в рацион вводятся кисломолочные продукты.
В мазке из цервикального канала
В цервикальный канал кишечная палочка проникает из кишечника после акта дефекации. При отсутствии должной гигиены и частого ношения синтетического белья риск инфицирования значительно возрастает. Женщина может длительное время не подозревать о поражении микроорганизмами. А первые симптомы могут восприниматься за проявления молочницы. Бактерии вызывают зуд, раздражение и покраснение вульвы и влагалища.
У мужчин
Поводом для взятия мазка у мужчин могут быть жалобы на боли и рези в области уретры, появление патологических выделений из уретры, покраснение наружного зева мочеиспускательного канала, сыпь на половом члене, боли во время интимной близости. При легкой форме заражения возникает мужская молочница. Причиной тому может стать незащищенный секс или несоблюдение гигиены.
Для предотвращения кандидоза следует пользоваться гелями для интимных зон и обязательно принимать душ после полового контакта с использованием бактерицидных средств. Врач может назначить мазок и при отсутствии жалоб. Исследование показано при обследовании пары по поводу бездетности, перед урологическими манипуляциями, а также выявлении вагинита у половой партнерши.
Если кишечная палочка была выявлена случайно и мужчину ничего не беспокоит, такое носительство не требует специфического лечения. Если в мазках были выявлены признаки воспаления, дополнительно необходимо сделать ПЦР-тест на скрытые инфекции, а также посев отделяемого.
У детей
Чаще всего причиной заражения в детском возрасте становится употребление грязных овощей или овощей, а также непригодной питьевой воды. Инфицирование новорожденных может происходить при искусственном вскармливании через плохо вымытую посуду или молочную смесь. Антисанитарные условия проживания – это еще один провоцирующий фактор эшерихиоза.
Особую опасность заболевание представляет для грудничков. Активное размножение патогенов чревато сильным обезвоживанием. Существует вероятность развития смертельного исхода. Инкубационный период длится от нескольких часов до восьми дней. Стул становится жидким с желтоватым или даже оранжевым оттенком.
Появляется рвота, вздутие, урчание в животе, боли, а также повышается температура тела. На обезвоживание указывает появление сухости кожи и слизистых оболочек, редкое мочеиспускание, плач без слез, а также потеря веса. Ребенок должен соблюдать постельный режим и диетическое питание. Лечить детей до двух лет при средней степени тяжести следует в условиях стационара.
Период беременности
Период вынашивания ребенка создает благоприятные условия для активного роста патогенных микроорганизмов. Женский организм испытывает физиологический стресс, который приводит к естественному снижению иммунной системы.
Эширихиоз при беременности способен вызвать опасные последствия. Бактерии могут привести к раннему отхождению околоплодных вод. Это чревато прерыванием беременности или преждевременным родам. Из влагалища патогены могут проникнуть через плацентарный барьер в кровеносное русло плода. Это может привести к врожденным патологиям. Кишечная палочка часто становится причиной менингита у ребенка.
Заражение малыша происходит во время прохождения по родовым каналам. Это чревато отставанием в развитии или даже летательным исходом. Обойтись без антибиотиков в лечении кишечной палочки просто невозможно. Гинекологи всегда подбирают для беременных женщин безопасные антибактериальные средства. Вспомогательную помощь окажут настои лекарственных трав для проведения подмываний. Можно использовать календулу, череду, ромашку.
Лечение
Избавиться от кишечной палочки можно с помощью антибиотиков. Они подбираются с учетом результатов микробиологического и бактериологического исследования. Медикаментозная терапия также включает в себя применение бактериофагов, пробиотиков, а также инфузии детоксикационных растворов.
Вылечить эширихиоз можно с помощью таких препаратов:
- Монурал. Выпускается в виде гранулированного порошка, который перед применением разводят с водой. В состав Монурала входят производные фосфоновой кислоты. Это препарат широкого спектра действия. При необходимости он может даже применяться беременными женщинами.
- Супракс. Выпускается в виде капсул. Это мощный и достаточно агрессивный антибиотик, активным компонентом которого является цификсим.
- Фосмицин. Является аналогом Монурала и также обладает широким спектром терапевтического действия. Фосмицин не применяется в лечении беременных, а также детей до двенадцати лет.
При выявлении кишечной палочки в мазке, порой обойтись можно местным лечением. Оно подразумевает правильную и регулярную гигиену наружных половых органов. Терапия может подразумевать лечебные спринцевания. Врачи также часто назначают влагалищные свечи с антисептическим действием. При инфекционных патологиях больным показана щадящая диета.
Разрешены овощи, отварное мясо, рыба, йогурт, кефир, слизистые каши и супы на воде. В период лечения придется исключить жареные, жирные, острые блюда, маринады, копчености. Также придется отказаться от цельного молока и свежих фруктов. Если вы не хотите в будущем заразиться кишечной палочкой, не забывайте о простых рекомендациях. Женщинам крайне важно соблюдать туалетную гигиену.
Промежность следует протирать спереди назад, но не наоборот. После посещения туалета, контакта с животными, а также перед приемом пищи и приготовлением еды следует тщательно мыть руки. Употребляйте пастеризованное молоко. Не употребляйте продукт в сыром виде. Для обработки мяса должна использоваться отдельная разделочная доска.
Итак, кишечная палочка присутствует в организме каждого человека. Существует большое количество штаммов бактерий, некоторые из которых являются патогенными и вызывают инфекционные заболевания. Лучшей профилактикой эширихиоза является регулярное мытье рук и соблюдение интимной гигиены. Заболевание проявляется в виде диареи, тошноты, рвоты, болей в животе.
Бактерии выделяют эндотоксины, что проявляется в виде симптомов интоксикации. У больных повышается температура, появляется слабость, апатия, головные боли, головокружение. При появлении первых симптомов эширихиоза следует незамедлительно обратиться к специалисту и следовать всем его рекомендациям!
Все чаще и чаще мы слышим о кишечных заболеваниях, они окружают нас отовсюду. Радио, телевидение, газеты — все заставляют нас паниковать, нагоняет страх. Но, как говорят, если знать врага в лицо, то он уже не так страшен. Поэтому, давайте, попробуем разобраться.
Что такое кишечная палочка.
Прежде всего кишечная палочка – это микроорганизм, который живет в кишечнике человека и животного. Кишечная палочка имеет научное название Escherichia coli. На протяжении долгого времени кишечная палочка может жить на почве, в фекалиях, а также в воде. Благоприятной средой для размножения являются продукты питания. Наиболее подходящий продукт — молоко.
Погибает этот микроорганизм при кипячении. Чувствителен он к дезинфицирующим средствам и к солнечному свету.
Что такое штаммы
Штаммы – это термин, который употребляется микробиологии. Нужен он, чтобы отличать образцы вирусов или культуры микробов одного названия, но разные по происхождению. Другими словами, в нашем случае, это другие типы кишечной палочки. Видов кишечной палочки великое множество. Различают больше ста видов только патогенных (вызывающих заболевание) типов. Они выделены в 4 класса.
- Энтеропатогенные – обозначают такие кишечные палочки, как ETEC. Зачастую они вызывают кишечные болезни тонкой кишки детей до 1 года и новорожденных. Сопровождаются они поносом и водяным стулом, болями в животе и рвотой.
- Энтеротоксигенные – такой вид палочки, который крепится к клеткам эпителия тонкой кишки. Они производят яды, которые являются главной причиной диарей у детей и взрослых.
- Энтероинвазивные – обозначают EIEC. Кишечные палочки этого вида обитают в ободочной кишке. Они вызывают периодические вспышки пищевого отравления у детей и взрослых. Способны побеждать защитные силы организма.
- Энтерогеморрагические – обозначаются EHEC. Это один из опасных видов кишечной палочки.Он вызывает тяжелое заболевание – геморрагический колит. Который характеризуется сильными, со спазмами, болями в животе, диареей (иногда кроваваой). Повышается температура тела до 39°. Иногда происходит осложнение в виде почечной недостаточности. Заразиться можно через продукты или контактируя с инфицированным человеком или животным.
Биология и биохимия кишечной палочки
Кишечная палочка E.coli – бактерия, которая живет и размножается без доступа кислорода и не образует эндоспор. Производит в результате жизнедеятельности углекислый газ и другие газы. Выделяя молекулярный водород. Клетки имеют вид палочки с закругленными концами, размером — 0,4-0,8 на 1-3 мкм. Объем клетки обычно 0,6-0,7µm3 . Имеют специальные жгутики и могут передвигаться. Наиболее интенсивный рост происходит при температуре 37, а иногда и при 49 o .
Роль кишечной палочки в нормальной микрофлоре
У человека количество этих микроорганизмов не превышает 1% от всех остальных микроорганизмов, живущих в кишечнике. Кишечная палочка – это такой страж, который не пропускает в кишечник другие опасные микробы. Она, используя кислород, создает условия для жизни бифидобактерий, которые необходимы человеку. И, что самое главное, этот полезный микроорганизм вырабатывает витамины B и K. Активно участвует и в процессах обмена жирных кислот, благодаря чему легче происходит всасывание кальция и железа.
Патогенность кишечной палочки
Способность микроорганизмов вызывать болезни человека носит название – патогенности микроорганизмов. Когда кишечная палочка попадает не кишечник, а в другой орган, то может вызвать инфекционное заболевание того органа, в который попала. Так, когда микроорганизм попадает в брюшную полость – возникает перитонит. Это воспаление брюшной полости, которое может привести и к смерти человека. Когда E.coli попадает в женские половые органы, она вызывает кольпит. Это когда происходит воспаление в слизистой влагалища. Если палочка попадает в предстательную железу мужчины, то естественно вызывает воспалительные процессы, которое сказывается на всей мочеполовой системе.
Причины желудочно-кишечных инфекций
Инфекции, которые вызывают заболевания ЖКТ, называют кишечными. Это могут быть такие заболевания как, гастрит, панкреатит, колит. После того, как в организм человека попадает, например, кишечная палочка, она начинает размножаться. Это приводит к тому, что пищеварительный процесс нарушен, слизистые оболочки кишечника воспаляются. В результате чего – понос. Необходимо помнить, что понос зачастую сопровождается обезвоживанием организма. Это очень опасно, потому как, вместе с потерей воды теряются и необходимые для человека соли. Такие соли, как калий, кальций, натрий обеспечивают нормальную работу организма. Основная причина таких инфекций – банальна. Это нарушение санитарных и гигиенических норм. Недостаточная очистка воды. Некачественные продукты и ненадлежащее их хранение и использование. Также очень часто инфекция заносится фекально-оральным способом ( через рот, грязные руки).
Что представляет собой лечение фагами
Прежде всего, надо разобраться, что такое бактериофаги? Это естественные враги бактерий. Так сказать, вирусы – «поедатели» бактерий. Надо отметить, что каждый вид фага уничтожает только «свой» вид. И после того, как все «цели» обезврежены, они выводятся из организма. Происходит лечение примерно так. Запускают в человека вирус — охотник, тот выполняет свою функцию и сам выводится из организма. Их рекомендуют применять вместо антибиотиков. Так они намного безопаснее. Большое применение нашли фагам при лечении детей.
Существует ли вакцина против кишечной палочки
Вакцина — это препарат, изготовленный из убитых или ослабевших микроорганизмов. Он предназначен создавать иммунитет к инфекционным заболеваниям. В 2009 году была создана такая вакцина учеными города Мичиган. Ученые преодолели молекулярный размер токсина, который выделяется кишечной палочкой. Именно такой маленький размер и был причиной того, что иммунная система не распознавала его. Месси Саид, профессор — эпидемиолог, создатель вакцины, произвел некий носитель и присоединил его к токсину. В результате, при вводе токсина в организм, иммунная система распознает его и реагирует.
- Боль в животе
- Вздутие живота
- Запор
- Изменение запаха каловых масс
- Кровь в кале
- Неприятный запах изо рта
- Повышенная температура
- Понос
- Потеря аппетита
- Рвота
- Слабость
- Сонливость
- Тошнота
Кишечной палочкой (Escherichia coli) учёные называют палочковидную условно-патогенную бактерию, которая способна нормально функционировать и размножаться только в условиях отсутствия кислорода. Была открыта в восемнадцатом веке Теодором Эшерихом, благодаря которому и получила своё название.
Бактерия имеет довольно много штаммов (разновидностей) и большинство из них считаются безвредными (они живут в кишечнике человека, участвуют в синтезировании витаминоподобных соединений, обладают бактерицидными свойствами по отношению к некоторым патогенным микроорганизмам), но встречаются и такие, которые могут вызывать развитие серьёзных проблем со здоровьем, начиная с нарушений работы ЖКТ и заканчивая развитием сепсиса, поэтому лечение кишечной палочки должно быть качественным и своевременным.
Общие сведения
Безопасные штаммы этого микроорганизма обитают в кишечнике человека, при этом их количество варьирует от 10 6 до 10 8 КОЕ (микробиологический показатель – колониеобразующая единица) на один грамм содержимого кишечника. Сразу стоит рассказать о том, что бактерии заселяют организм человека в первые дни после рождения, поэтому кишечные палочки у грудничков появляются сразу, и в том случае если их количество не превышает норму, они приносят кишечнику пользу, а значит, лечить такое состояние не нужно.
Однако стоит помнить, что некоторые штаммы этого микроорганизма токсичны, особенно для детей и беременных женщин (кишечная палочка в моче при беременности может свидетельствовать о развитии острого или хронического инфекционного заболевания, угрожающего здоровью плода), так что очень важно вовремя диагностировать это состояние и назначить адекватное лечение.
Кишечные палочки бывают условно-патогенные (к которым относится гемолизирующая кишечная палочка) и патогенные. Учёные смогли выделить больше сотни патогенных штаммов этой бактерии, которые впоследствии были разделены на четыре основных класса, а именно:
- энтероинвазивные;
- энтеротоксигенные;
- энтеропатогенные;
- энтерогеморрагические.
Эти микроорганизмы могут стать причиной развития эшерихиозов – заболеваний инфекционного характера, которые по статистике чаще всего встречаются у детей и женщин (инфекция передаётся фекально-оральным путём в основном через пищу или воду).
Симптомы
Симптомы заражения кишечной палочкой проявляются по-разному, поэтому каждый класс патогенных бактерий необходимо рассматривать в отдельности. Состояние здоровья заражённого человека будет зависеть от того, в какую группу относятся и с какой скоростью размножаются кишечные палочки, симптомы заболеваний описаны ниже.
Энтеропатогенные бактерии
Энтеропатогенные микроорганизмы чаще всего встречаются у детей до одного года жизни и их присутствие, как правило, обнаруживается ещё в роддоме. Сопровождаются водянистой диареей, иногда рвотой, отказом от еды и беспокойным сном.
Энтеротоксигенные бактерии
Энтеротоксигенные кишечные палочки опасны тем, что могут прикрепляться именно к слизистой оболочке кишечника, чем существенно нарушают его работу. Инфекция передаётся через немытые руки или фрукты, поэтому симптомы жизнедеятельности кишечных бактерий в человеческом организме иногда называют «диареей путешественника», которая сопровождается водянистым поносом без крови, тошнотой, приступообразной болью в животе.
Энтерогеморрагические бактерии
Энтерогеморрагические эшерихиозы характеризуется диареей с примесью крови и сопровождаются развитием острой гемолитической анемии. Опасность заболевания состоит в том, что гемолитическая кишечная палочка разрушает кровяные тельца, а это может привести к летальному исходу (чаще всего болезнь поражает женщин). Характерным признаком заболевания является то, что в каловых массах обнаруживается большое количество слизи и примесей зеленоватого оттенка, при этом гемолизирующая кишечная палочка не вызывает повышения температуры тела.
Энтероинвазивные бактерии
Энтероинвазивные патогенные микроорганизмы вызывают боли внизу живота и обильный стул (иногда с примесью крови). Встречаются в основном у детей, временно нарушают работу иммунной системы. Следует сказать о том, что чёткой клинической картины эшерихиозов не существуют, пациенты жалуются на боли в животе (которые могут быть локализованы в любой его части), жидкий стул и рвотные позывы, следовательно, лечение кишечных палочек должно быть комплексным и обязательно проходить под контролем врача. Кстати говоря, лактозонегативная кишечная палочка не должна обнаруживаться в кале в слишком больших количествах (норма – 10 5 ), а увеличение этого показателя можно заметить даже самостоятельно, об этом свидетельствуют непереваренные кусочки пищи в кале и чередование диареи с запорами.
Кишечная палочка, как возбудитель заболеваний мочеполовой системы
В норме кишечная палочка в моче обнаруживаться не должна, но если при сдаче анализов она была там найдена, врач должен в срочном порядке заняться её лечением. Обычно этот микроорганизм обнаруживается врачами-гинекологами при осмотре беременных женщин, причём для многих наличие этого микроорганизма в микрофлоре влагалища становится сюрпризом. Обнаруженная кишечная палочка в мазке свидетельствует о начале развития воспалительного процесса одного или нескольких органов мочеполовой системы (существует вероятность того, что бактерия передаётся половым путём от одного партнёра к другому).
Нужно сказать о том, что кишечная палочка во влагалище, должна стать поводом к тому, чтоб из лаборатории, сразу же отправиться в кабинет к врачу. Дело в том, что она существенно ослабляет местный иммунитет и делает организм больного человека практически беззащитным перед другими опасными бактериями, например, перед протеусом или стафилококком, что в итоге может стать причиной развития гонореи или хламидиоза, следовательно, лечить это состояние должен только специалист.
Гемолизирующая кишечная палочка является причиной развития 80% заболеваний мочеполовой системы, к которым относится:
- острый и хронический простатит у мужчин (кишечная палочка в мазке при диагностике простатита обнаруживается практически в 65% случаев);
- воспаление яичников и придатков у женщин;
- цистит;
- вагинит (если кишечная палочка в мазке на вагинит обнаруживается сразу, то лечение этого недуга проходит максимально быстро, а отсутствие адекватной терапии может стать причиной развития серьёзных проблем со здоровьем);
- пиелонефрит (очень часто гемолизирующая кишечная палочка обнаруживается при диагностике пиелонефрита у беременных);
- кольпит и так далее.
На самом деле в гинекологии гемолизирующая кишечная палочка занимает особенное место, потому что при попадании во влагалище она провоцирует развитие ряда таких заболеваний, которые впоследствии приводят к бесплодию и трудно поддаются лечению. По этой причине врачи советуют делать профилактику и диагностику этого возбудителя (определяется кишечная палочка в мазке) хотя бы один раз в год.
Как лечить?
Лечить кишечную палочку должен врач, который вначале делает бактериальный посев и точно определяет штамм возбудителя. Интенсивность и длительность лекарственной терапии зависит от вида бактерии, её локализации и индивидуальных особенностей организма больного человека. В процессе лечения важную роль играет диета и приём пробиотиков – препаратов, нормализующих кишечную микрофлору. После окончания курса лекарственной терапии все анализы сдаются повторно.